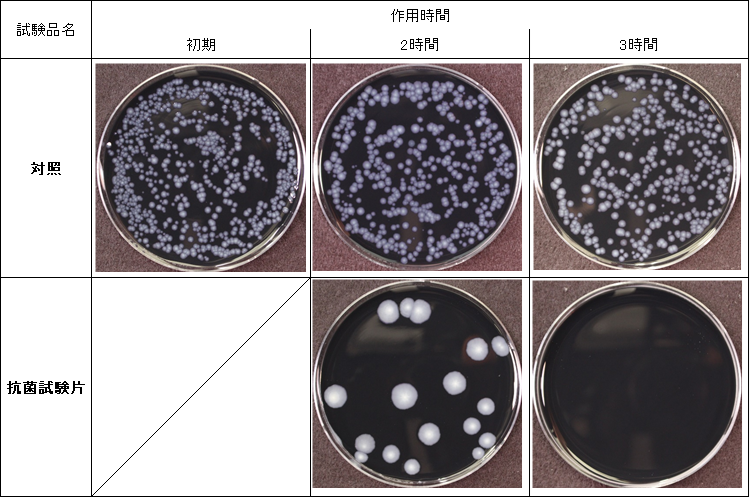

1. 概要
当センターではJIS規格やISO規格等に準拠して加工製品等の各種微生物※1・ウイルス※2に対する有効性を評価します。試験によっては、基準を満たすことで各種認証マーク※3を取得できるものもあります。
※1 菌株保有リスト ※2 ウイルス保有リスト ※3 情報館ページ「各種認証マークについて」をご確認ください。
2. 対象品目
・抗菌加工製品(プラスチック、金属、セラミック等)
・抗かび加工製品(プラスチック、金属、セラミック等)
・抗ウイルス加工製品(プラスチック、金属、セラミック等)
・その他の製品(素材単体含む)
3. 規格・法律等
・JIS Z 2801 抗菌加工製品-抗菌性試験方法・抗菌効果
・JIS Z 2811 繰り返し除菌性試験
・JIS L 1902 繊維製品の抗菌性試験方法及び抗菌効果
・JIS L 1921 繊維製品の抗かび性試験方法及び抗かび効果
・JIS Z 2911 かび抵抗性試験方法
・JIS R 1702、1752、1705、1706、1756等の光触媒抗菌加工製品の各種試験
・ISO 21702 プラスチック及びその他の非多孔質表面の抗ウイルス活性の測定
・ISO 18184(JIS L 1922) 繊維製品の抗ウイルス性試験方法
4. 試験・検査方法
・製品の抗菌性、抗かび性、抗ウイルス性試験
製品に微生物を接種して所定時間作用させ、残存する微生物数を測定して抗菌性、抗かび性あるいは抗ウイルス性を評価します。
・かび抵抗性試験
製品にかびの胞子を接種して所定期間培養し、かびの発育状態から防かび性を評価します。
・繰り返し除菌性試験
製品に微生物を接種して所定時間作用させることを複数回行い、製品に負荷をかけます。負荷をかけた製品に微生物を接種して所定時間作用させ、残存する微生物数を測定して抗菌性を評価します。詳細な試験方法は、情報館ページ「JIS Z 2811:2021 繰り返し除菌性試験方法について」、をご確認ください。
試験規格以外の試験についても、現在までに実施した多くの試験実績及び科学的な知見を基に適切な試験設計をご提案し、ご依頼者様のご要望にあった試験を致します。